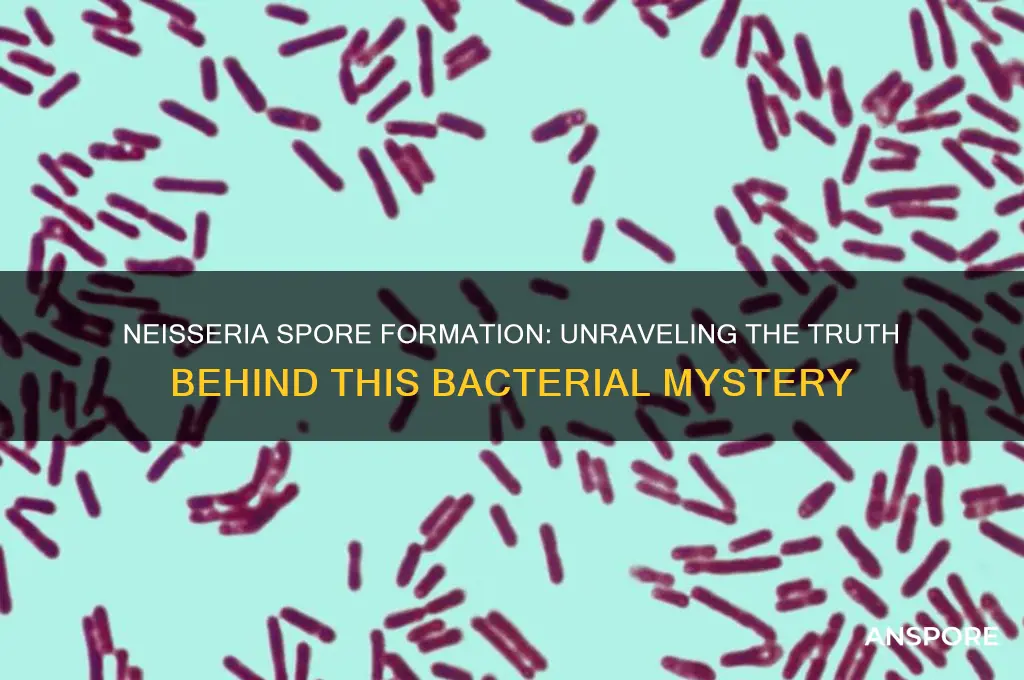
does neisseria form spores

Neisseria, a genus of Gram-negative bacteria known for causing diseases such as gonorrhea and meningococcal meningitis, is primarily characterized by its diplococcal morphology and requirement for specific growth conditions. Unlike spore-forming bacteria, which produce highly resistant endospores to survive harsh environments, Neisseria lacks the ability to form spores. This absence of spore formation is a defining feature of the genus, as it relies on its ability to thrive in specific niches, particularly mucosal surfaces of humans, rather than enduring extreme conditions. Understanding this distinction is crucial for studying its biology, pathogenicity, and susceptibility to antimicrobial agents.
| Characteristics | Values |
|---|---|
| Spore Formation | No, Neisseria species do not form spores. |
| Cell Shape | Cocci (spherical), typically appearing in pairs (diplococci). |
| Gram Staining | Gram-negative. |
| Motility | Non-motile. |
| Oxygen Requirement | Aerobic or facultatively anaerobic. |
| Optimal Growth Temperature | 35-37°C (human body temperature). |
| Habitat | Mucous membranes of humans and animals, primarily in the respiratory and urogenital tracts. |
| Pathogenicity | Some species are pathogenic, e.g., Neisseria gonorrhoeae (causes gonorrhea) and Neisseria meningitidis (causes meningitis and sepsis). |
| Metabolism | Requires preformed factors like iron and certain amino acids for growth. |
| Capsule | Some species, like N. meningitidis, produce a polysaccharide capsule. |
| Sporulation Genes | Absent, as Neisseria lacks the genetic machinery for spore formation. |
| Clinical Significance | Important in diagnosing and treating infections, particularly in sexually transmitted and systemic diseases. |
Explore related products
What You'll Learn
- Neisseria's Reproductive Methods: Neisseria reproduces asexually via binary fission, not spore formation
- Spore Formation Definition: Spores are dormant, resistant structures formed by some bacteria, not Neisseria
- Neisseria's Survival Strategies: Neisseria relies on biofilm formation and host adaptation, not spore production
- Bacterial Genera That Form Spores: Examples include Bacillus and Clostridium, unlike Neisseria
- Environmental Resistance in Neisseria: Neisseria is fragile outside hosts, lacking spore-like protective mechanisms

Neisseria's Reproductive Methods: Neisseria reproduces asexually via binary fission, not spore formation
Neisseria, a genus of gram-negative bacteria, does not form spores as part of its reproductive strategy. This is a critical distinction, as spore formation is a survival mechanism employed by certain bacteria to endure harsh environmental conditions, such as extreme temperatures, desiccation, or lack of nutrients. Instead, Neisseria relies on a different method to propagate and maintain its presence in various environments, particularly within the human body. Understanding this reproductive method is essential for comprehending the bacterium's lifecycle and its implications in clinical settings.
The primary reproductive mechanism of Neisseria is binary fission, a form of asexual reproduction where a single bacterial cell divides into two identical daughter cells. This process begins with the replication of the bacterium's circular DNA, followed by the cell elongating and the cell wall and membrane invaginating inward, eventually separating the two daughter cells. Binary fission allows Neisseria to rapidly multiply under favorable conditions, such as within the warm, nutrient-rich environment of the human mucous membranes. For instance, Neisseria gonorrhoeae, the causative agent of gonorrhea, can double its population every 1.5 to 3 hours under optimal conditions, highlighting the efficiency of this reproductive method.
While binary fission is highly effective for proliferation, it lacks the long-term survival benefits of spore formation. Spores, produced by bacteria like Bacillus and Clostridium, are highly resistant structures that can remain dormant for years, waiting for conditions to improve before reactivating. In contrast, Neisseria is more vulnerable to environmental stresses, relying on its ability to colonize and persist within a host for survival. This vulnerability is why Neisseria species are typically found in specific niches within the human body, such as the mucosal surfaces of the genitourinary and respiratory tracts, where they can thrive and evade the host immune system.
Clinically, the absence of spore formation in Neisseria has significant implications for infection control and treatment. Since Neisseria does not produce spores, standard disinfection methods that target vegetative cells are generally effective against it. For example, ethanol-based hand sanitizers and quaternary ammonium compounds can effectively kill Neisseria cells on surfaces and hands. However, the bacterium's ability to rapidly multiply and form microcolonies within the host necessitates prompt and effective treatment of infections. Antibiotics such as ceftriaxone (typically administered as a single 250 mg intramuscular dose) and azithromycin (1 g orally) are commonly used to treat gonococcal infections, targeting the actively dividing cells.
In summary, Neisseria's reproductive strategy hinges on binary fission, a method that enables rapid multiplication but lacks the survival advantages of spore formation. This distinction shapes the bacterium's ecological niche, vulnerability to environmental stresses, and clinical management. By understanding these reproductive methods, healthcare professionals can better address Neisseria infections, emphasizing timely treatment and effective disinfection practices to control their spread.
UV Light vs. Mold Spores: Effective Solution or Myth?
You may want to see also

Spore Formation Definition: Spores are dormant, resistant structures formed by some bacteria, not Neisseria
Spores are a survival mechanism employed by certain bacteria to endure harsh environmental conditions. These structures are dormant, highly resistant, and can persist for extended periods, even in the absence of nutrients or under extreme temperatures. Notably, spore formation is not a universal bacterial trait; it is specific to certain genera, such as *Bacillus* and *Clostridium*. This distinction is crucial when considering *Neisseria*, a genus that lacks the ability to form spores. Understanding this difference is essential for microbiologists and healthcare professionals, as it influences how these bacteria are treated and controlled in clinical and laboratory settings.
From a practical standpoint, the absence of spore formation in *Neisseria* has significant implications for disinfection and sterilization protocols. Spores of spore-forming bacteria, like *Bacillus anthracis*, require more stringent methods, such as autoclaving at 121°C for 15–30 minutes, to ensure their destruction. In contrast, *Neisseria* species, including *N. gonorrhoeae* and *N. meningitidis*, are more susceptible to standard disinfection techniques, such as ethanol-based sanitizers or heat treatment at 70°C for 10 minutes. This knowledge allows for the implementation of targeted and efficient infection control measures, particularly in healthcare environments where *Neisseria* infections are prevalent.
Comparatively, the inability of *Neisseria* to form spores highlights its reliance on immediate host environments for survival. Unlike spore-forming bacteria, which can disperse widely and remain viable in soil or water, *Neisseria* species are primarily transmitted through close contact, such as sexual activity or respiratory droplets. This limitation underscores the importance of behavioral interventions, such as safe sex practices and vaccination (e.g., the meningococcal vaccine), in preventing *Neisseria*-related diseases. By contrast, controlling spore-forming pathogens often requires environmental decontamination, emphasizing the distinct epidemiological approaches needed for these two groups.
For laboratory researchers, the absence of spore formation in *Neisseria* simplifies cultivation and experimentation. While spore-forming bacteria necessitate specific techniques, such as heat shock or extended incubation, to activate spores before growth, *Neisseria* can be cultured directly on enriched media like chocolate agar. This straightforward process allows for quicker identification and analysis, which is particularly valuable in diagnostic settings. However, researchers must remain vigilant about contamination risks, as *Neisseria*’s non-spore-forming nature does not preclude its sensitivity to environmental stressors, such as desiccation or prolonged exposure to air.
In summary, the definition of spore formation as a dormant, resistant bacterial structure excludes *Neisseria*, a genus with distinct survival strategies. This exclusion has practical ramifications for disinfection, disease transmission, and laboratory practices. By recognizing these differences, professionals can tailor their approaches to effectively manage *Neisseria* infections while distinguishing them from the challenges posed by spore-forming bacteria. This nuanced understanding is key to advancing both clinical care and microbiological research.
Are Spore-Grown Plants Harmful? Unveiling the Truth About Their Safety
You may want to see also

Neisseria's Survival Strategies: Neisseria relies on biofilm formation and host adaptation, not spore production
Neisseria, a genus of gram-negative bacteria, has evolved sophisticated survival strategies to thrive in diverse environments, particularly within human hosts. Unlike spore-forming bacteria such as Bacillus or Clostridium, Neisseria does not produce spores as a survival mechanism. Instead, it relies on two primary strategies: biofilm formation and host adaptation. These approaches allow Neisseria species, including *Neisseria gonorrhoeae* and *Neisseria meningitidis*, to persist in hostile conditions, evade immune responses, and establish chronic infections.
Biofilm formation is a cornerstone of Neisseria's survival toolkit. Biofilms are structured communities of bacteria encased in a self-produced extracellular matrix, which provides protection against antibiotics, host immune defenses, and environmental stressors. For instance, *N. gonorrhoeae* forms biofilms on mucosal surfaces, enhancing its ability to resist phagocytosis and antimicrobial agents. Studies have shown that biofilm-associated *N. gonorrhoeae* is up to 1,000 times more resistant to antibiotics like ceftriaxone compared to planktonic cells. To disrupt Neisseria biofilms, clinicians often combine antibiotics with biofilm-disrupting agents, such as DNase or N-acetylcysteine, which degrade the extracellular matrix. This dual approach is particularly critical in treating drug-resistant gonorrhea, where biofilms contribute to treatment failure.
Host adaptation is another key survival strategy for Neisseria. These bacteria have evolved to exploit human host factors, such as transferrin and lactoferrin, for nutrient acquisition. For example, *N. gonorrhoeae* and *N. meningitidis* express surface proteins like transferrin-binding protein (TbpA/TbpB) to scavenge iron from host proteins, a critical process for their survival in iron-limited environments like the human mucosa. Additionally, Neisseria species modulate host immune responses through molecules like lipooligosaccharide (LOS), which mimics human cell surface antigens, leading to immune evasion. Vaccines targeting these surface proteins, such as the meningococcal conjugate vaccine, have been developed to prevent infections by disrupting host adaptation mechanisms.
Comparatively, the absence of spore formation in Neisseria highlights its reliance on active, host-dependent survival strategies. While spores allow bacteria like *Bacillus anthracis* to survive extreme conditions for years, Neisseria's approach is more dynamic, focusing on immediate adaptation and protection within the host. This distinction is crucial for understanding why Neisseria infections are typically localized and host-specific, whereas spore-forming bacteria can cause widespread, environmental outbreaks. For instance, gonorrhea and meningococcal disease are transmitted through close contact, whereas anthrax spores can persist in soil and be inhaled, leading to systemic infection.
In practical terms, understanding Neisseria's survival strategies informs treatment and prevention efforts. Clinicians should consider biofilm formation when treating recurrent or persistent infections, opting for prolonged antibiotic regimens or combination therapies. Public health initiatives should focus on vaccination and safe sexual practices to limit host adaptation and transmission. For example, the CDC recommends a single dose of meningococcal vaccine for adolescents aged 11–12 years, with a booster at age 16, to prevent meningococcal disease. Similarly, consistent condom use reduces the risk of gonorrhea transmission by disrupting biofilm-mediated persistence on mucosal surfaces. By targeting Neisseria's unique survival mechanisms, healthcare providers can more effectively combat these resilient pathogens.
Unveiling the Role of Spores in Homeostatic Soil Organisms
You may want to see also
Explore related products
$27.25

Bacterial Genera That Form Spores: Examples include Bacillus and Clostridium, unlike Neisseria
Spores are a survival mechanism employed by certain bacteria to endure harsh environmental conditions, such as extreme temperatures, desiccation, and exposure to chemicals. Among the bacterial genera, Bacillus and Clostridium are well-known for their ability to form highly resistant spores. These spores can remain dormant for years, only to revive and resume growth when conditions become favorable. In contrast, Neisseria, a genus that includes pathogens like *Neisseria gonorrhoeae* and *Neisseria meningitidis*, does not form spores. This distinction is critical in understanding their survival strategies and clinical implications.
Consider the practical implications of spore formation in medical and industrial settings. Bacillus anthracis, the causative agent of anthrax, forms spores that can contaminate soil for decades, posing a persistent threat to livestock and humans. Similarly, Clostridium botulinum produces spores that survive in improperly canned foods, leading to botulism if ingested. These examples highlight the importance of spore-forming bacteria in public health. Conversely, Neisseria species rely on immediate host-to-host transmission and cannot persist outside the body for extended periods, making their control strategies fundamentally different.
From a laboratory perspective, identifying spore-forming bacteria is crucial for proper sterilization techniques. Autoclaving, a common method for sterilizing lab equipment, is effective against spores but requires specific conditions (121°C for 15–30 minutes). However, non-spore-forming bacteria like Neisseria are generally less resistant and can be inactivated by less stringent methods, such as 70% ethanol or heat treatment at 60°C for 30 minutes. Understanding these differences ensures appropriate handling and prevention of contamination in clinical and research environments.
Clinically, the inability of Neisseria to form spores influences treatment approaches. Since Neisseria species are non-spore-forming, they are typically susceptible to antibiotics that target actively growing cells, such as beta-lactams (e.g., ceftriaxone) and macrolides (e.g., azithromycin). In contrast, spore-forming bacteria like Clostridium difficile often require more aggressive treatment, including spore-targeting agents like vancomycin or fidaxomicin. This underscores the importance of distinguishing between spore-forming and non-spore-forming bacteria in therapeutic decision-making.
In summary, while Bacillus and Clostridium leverage spore formation to survive adverse conditions, Neisseria lacks this ability, relying instead on immediate transmission and host adaptation. This fundamental difference shapes their ecological niches, clinical management, and laboratory handling. Recognizing these distinctions is essential for effective infection control, treatment, and research, ensuring that strategies are tailored to the unique biology of each bacterial genus.
Buying Magic Mushroom Spores in Australia: Legalities and Options Explained
You may want to see also

Environmental Resistance in Neisseria: Neisseria is fragile outside hosts, lacking spore-like protective mechanisms
Neisseria, a genus of bacteria including pathogens like *Neisseria gonorrhoeae* and *Neisseria meningitidis*, is remarkably fragile outside its human host. Unlike spore-forming bacteria such as *Clostridium* or *Bacillus*, Neisseria lacks the ability to produce spores, which are highly resistant, dormant structures that protect bacteria from harsh environmental conditions. This vulnerability is a defining characteristic of Neisseria, shaping its transmission dynamics and survival strategies. Without spore-like mechanisms, Neisseria relies almost entirely on its host for survival, making it highly susceptible to desiccation, temperature extremes, and disinfectants.
This fragility has significant implications for infection control. For instance, *N. gonorrhoeae* can survive for only a few hours outside the body, typically on moist surfaces, and is rapidly inactivated by common antiseptics like 70% ethanol. Similarly, *N. meningitidis* is sensitive to drying and ultraviolet light, limiting its environmental persistence. These characteristics mean that Neisseria transmission is primarily person-to-person, often requiring direct contact with infected bodily fluids. Public health measures, such as hand hygiene and barrier protection, are therefore highly effective in preventing the spread of these pathogens.
From a comparative perspective, the absence of spore formation in Neisseria contrasts sharply with bacteria like *Bacillus anthracis*, which can persist in soil for decades as spores. This difference highlights Neisseria's evolutionary adaptation to a strictly human-centric lifestyle, trading environmental resilience for specialized host interaction. While this limits its survival outside hosts, it also makes Neisseria less likely to contaminate environmental reservoirs, reducing the risk of indirect transmission.
Practically, understanding Neisseria's fragility informs clinical and laboratory practices. For example, swabs for gonorrhea or meningococcal testing must be handled carefully to maintain sample viability, as the bacteria degrade quickly. In healthcare settings, surfaces contaminated with Neisseria can be effectively decontaminated using standard disinfectants, unlike spore-forming bacteria that may require more aggressive measures. This knowledge also underscores the importance of timely diagnosis and treatment, as the bacteria's short environmental lifespan limits the window for transmission.
In conclusion, Neisseria's lack of spore-like protective mechanisms renders it highly vulnerable outside its host, shaping its epidemiology and control strategies. This fragility, while limiting its environmental persistence, necessitates targeted approaches to prevent transmission and manage infections. By leveraging this unique characteristic, public health efforts can effectively mitigate the impact of Neisseria-related diseases.
Moss Spores vs. Sporangium: Unraveling the Tiny Reproductive Structures
You may want to see also
Frequently asked questions
No, Neisseria does not form spores. It is a non-spore-forming bacterium.
Neisseria is a gram-negative, coccoid bacterium that does not produce spores.
No, Neisseria lacks the genetic and structural mechanisms required for spore formation under any conditions.
Neisseria relies on its ability to remain viable in moist environments and on surfaces for short periods but does not form spores for long-term survival.
No, none of the Neisseria species, including N. gonorrhoeae and N. meningitidis, are capable of forming spores.






![Substances screened for ability to reduce thermal resistance of bacterial spores 1959 [Hardcover]](https://m.media-amazon.com/images/I/51Z99EgARVL._AC_UL320_.jpg)
























